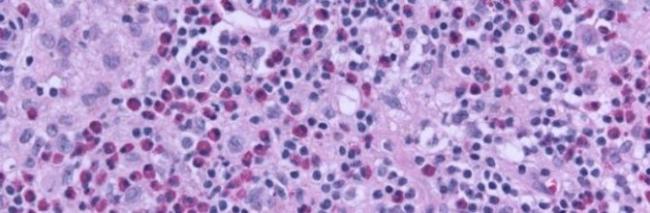
Эозинофилы у ребенка. норма, почему повышены, отсутствуют, понижены в крови. причины

Как повысить эозинофилы в крови?
Эозинопения не является самостоятельным заболеванием с типичными симптомами. Это всегда следствие развития заболевания в организме человека. Поэтому коррекция состояния эозинопении складывается из терапии основной болезни.
При установлении бактериальной инфекции врач назначает дополнительные анализы по выделению и идентификации вида возбудителя. Подобный подход необходим для точного подбора антибиотиков. Для этого проводится тест: воздействуют на выделенные бактерии различными группами антибиотиков. Пациенту назначается тот, который проявил максимальную эффективность.
После устранения бактериальной инфекции число эозинофильных гранулоцитов возвращается в пределы нормы.
Лечение синдрома гиперкортицизма направлено на нормализацию работы надпочечников.Это приводит к отмене токсического воздействия гормонов на организм. Препараты, дозировку и длительность курса подбирает лечащий врач для каждого пациента в отдельности.
Симптоматическое лечение гиперкортицизма сводится к:
- восстановлению нормального белкового и углеводного обмена;
- поддержанию нормального уровня артериального давления;
- подбору терапии сердечной недостаточности, при необходимости.
Терапия синдрома Гудпасчера складывается из назначения стероидных гормонов в больших дозах наряду с цитостатическими лекарствами. Их механизм действия направлен на приостановку процессов роста и деления всех клеток в организме человека, включая мутантные злокачественные новообразования.
Наряду с этим терапия предполагает грамотный подбор иммуностимулирующих лекарственных средств.
Подход к лечению ринита определяется его причиной. Коррекция нарушений гормонального баланса проводится медикаментозно, а психоэмоциональных травм – визитом к психологу или психотерапевту. При этом пациенту следует ограничить применение сосудосуживающих спреев.
Врачи отмечают, что нормальные значения эозинофилов в крови варьируются от 0 до 0,5×10^9/л. Повышение уровня этих клеток, известное как эозинофилия, может быть связано с различными факторами, включая аллергические реакции, паразитарные инфекции и некоторые аутоиммунные заболевания. В таких случаях эозинофилы активно участвуют в иммунном ответе, что может указывать на наличие воспалительного процесса. С другой стороны, понижение уровня эозинофилов, или эозинофилия, может возникнуть при острых инфекциях, стрессовых состояниях или при приеме определенных медикаментов, таких как кортикостероиды. Врачи подчеркивают важность комплексного подхода к диагностике, так как изменения в уровне эозинофилов могут служить индикатором различных заболеваний и требуют внимательного анализа клинической картины.
https://youtube.com/watch?v=OAYR2dDkVSw
Аллергия
Повышенные эозинофилы служат показателем острых или хронических аллергических процессов, развивающихся в организме. В России аллергия является самой частой причиной повышения в крови эозинофилов у ребенка.
Кроме повышенных эозинофилов, для пищевой аллергии характерна лейкопения, высокий уровень в крови у ребенка иммуноглобулинов IgE, присутствие EO в слизи из кала.
Существует взаимосвязь между степенью эозинофилии и выраженностью симптомов аллергии:
- при повышении EO до 7-8% — слабое покраснение кожи, незначительный зуд, увеличение лимфоузлов до «горошины», IgE 150 — 250 МЕ/л;
- EO повышены до 10% — сильный кожный зуд, появление трещин, корок на коже, выраженное увеличение лимфоузлов, IgE 250 – 500 МЕ/л;
- EO более 10% — постоянный зуд, нарушающий сон ребенка, обширные поражения кожи с глубокими трещинами, увеличение нескольких лимфоузлов до размеров «фасолины», IgE более 500 МЕ/л.
Повышены эозинофилы при поллинозе – аллергическом воспалении слизистых полости носа, околоносовых синусов, носоглотки, трахеи, бронхов, конъюнктивы глаз. Поллиноз проявляется отечностью слизистых, насморком, чиханием, отечностью век, заложенностью носа.
Повышенный уровень эозинофилов при поллинозе обнаруживается не только в периферической крови, но и в слизистых оболочках в очагах воспаления.
Аллергия на вакцинацию
Повышение эозинофильных гранулоцитов может возникать у детей в результате аллергической реакции на вакцинацию. Иногда за признаки осложнения вакцинации принимают заболевания, никак не связанные с введением вакцины.
О том, что эозинофилы повышены у ребенка именно по причине введения вакцины, говорит появление симптомов осложнения не позже, чем:
- через 2 суток для прививок АДС, АКДС, АДС-С – вакцин от дифтерии, коклюша, столбняка;
- 14 суток при введении прививки от кори, симптомы осложнения появляются чаще на 5 день после вакцинации;
- 3 недели при прививке от паротита;
- 1 месяц после прививки против полиомиелита.
Немедленное осложнение вакцинацию – анафилактический шок, сопровождается повышенными эозинофилами, лейкоцитами, эритроцитами, нейтрофилами. Анафилактический шок на вакцинацию развивается в первые 15 минут после введения препарата, проявляется у ребенка:
- беспокойством, тревожностью;
- частым слабым пульсом;
- одышкой;
- бледностью кожи.
Норма эозинофилов в крови составляет от 0 до 5% от общего числа лейкоцитов. Повышение их уровня, известное как эозинофилия, может указывать на различные проблемы со здоровьем. Чаще всего это связано с аллергическими реакциями, инфекциями, вызванными паразитами, или аутоиммунными заболеваниями. Люди, страдающие от астмы или аллергий, часто замечают увеличение эозинофилов в анализах. С другой стороны, понижение уровня этих клеток, или эозинофилия, может быть следствием стресса, инфекций или приема определенных медикаментов. Важно помнить, что любые изменения в анализах крови требуют консультации врача для определения точной причины и назначения соответствующего лечения.

Причины эозинофилии
Высокий уровень эозинофилов в крови указывает на аллергическую напряженность организма, что может являться следствием таких состояний, как:
-
Аллергическая реакция реактивного типа (сенная лихорадка, отек Квинке, крапивница).
-
Аллергический насморк.
-
Кожные аллергические реакции (экзема, контактный и атопический дерматит, пузырчатка обыкновенная).
-
Паразитарные инвазии (заражение амебами, хламидиями, токсоплазмами).
-
Глистные инвазии.
-
Системные заболевания (красная волчанка, ревматоидный артрит, фасциит, узелковый периартериит).
-
Острые и хронические инфекционные заболевания (сифилис, вирус Эпштейна-Барра, туберкулез).
-
Болезни легких (астма, саркоидоз, плеврит эозинофильной природы, фиброзирующий альвеолит, болезнь Лефлера, гистоцитоз).
-
Онкологические болезни крови (лимфома, лимфогранулематоз).
-
Болезни пищеварительной системы (гастрит и колит эозинофильной природы).
При обнаружении эозинофилии, взрослого больного направляют на сдачу следующих анализов:
-
Кал на яйца глистов.
-
Кровь для проведения биохимического анализа.
-
Ультразвуковое исследование органов брюшной полости.
Также пациент обязательно должен посетить аллерголога, на усмотрение врача возможно проведение следующих исследований:
-
Мазок из зева и носовых ходов на определение уровня эозинофилов, если у человека имеется аллергический насморк.
-
Выполнение провокационных проб и спирометрии при подозрении на астму.
-
Выявление аллергенов по сыворотки крови.
В дальнейшем пациент получает врачебные рекомендации и лечится от имеющегося у него заболевания. Если у больного поражены легкие, то его направляют на консультацию к пульмонологу. При паразитарных инвазиях необходимо отправиться на прием к инфекционисту.
Определение эозинофилии и эозинопении
Предупредить серьёзные проблемы со здоровьем проще, когда заболевание определяется на ранней стадии. По этой причине рекомендуется самому человеку внимательно следить за своим самочувствием, не игнорировать те «весточки», которые посылает организм, предупреждая о зарождении проблемы.

Возможная симптоматика
Явных симптомов эозинофилии как таковых не существует, поскольку такое отклонение не является самостоятельным заболеванием. Именно по этой причине в качестве симптоматики рассматриваются признаки, характерные основной патологии.
Итак, если эозинофилы в крови будут увеличиваться по причине глистной инвазии, больной будет замечать такие признаки:
- кашель;
- кожная сыпь;
- потеря массы тела;
- суставная боль;
- снижение аппетита;
- субфебрильная лихорадка;
- анемия;
- увеличение лимфоузлов, печени.
Суставная боль в локте
Если проблема вызвана заболеваниями ЖКТ, наблюдаются дополнительно:
- тошнота;
- рвота;
- диарея;
- присутствие гноя или крови в кале.
Диагностика отклонений
Чтобы получить достоверные результаты, врачи информируют пациентов, как и при каких условиях будет проводиться общий анализ крови на выявление количества эозинофилов.
Проблема заключается в том, что количество исследуемых кровяных клеток варьируется в течение суток, а также зависит от функции надпочечников.
В частности, у каждого человека наблюдается рост количества:
- в утренний период, вследствие этого показатель превышает норму на 10%;
- в вечерний период и первую половину ночи, провоцируя превышение нормы на 30%.
Для получения достоверных результатов рекомендуется:
- кровь сдавать утром, исключая любой приём пищи;
- воздержаться от употребления сладкого в течение предшествующих суток;
- исключить употребление спиртных напитков минимум за одни сутки до проведения исследования;
- отказаться от курения также за 24 часа.
Девушки должны сдавать кровь на 5 – 6 день менструального цикла.
Во врачебной практике различают три степени эозинофильного увеличения:
- лёгкая (от 1 до 10%);
- умеренная (от 11 до 19%);
- выраженная (от 20% и выше).
Врачи не делают поспешных заключений, внимательно изучают результаты исследования, обращая внимание на обозначения, общие показатели лейкоцитов. При необходимости врачи могут назначить повторное проведение исследования крови, чтобы убедиться в достоверности результатов, подтвердить наличие проблемы
Как привести уровень эозинофилов в норму
Если результаты нескольких анализов подтвердили проблему, лечащий врач разрабатывает схему лечения эозинофилии.
Курс лечения обязательно предусматривает устранение основного заболевания. В частности, могут быть назначены:
- противоглистные препараты;
- антигистаминные средства;
- энтеросорбенты;
- цитостатики;
- гормоны;
- иммунодепрессанты
- антибактериальные средства.
Также вне зависимости основной причины, спровоцировавшей эозинофилию, больным назначают витамины, препараты железа, а также рекомендуют соблюдать правильное питание, чтобы укрепить иммунитет.
Эозинофилы у беременных
В период беременности показатели эозинофилов могут отличаться от тех, которые характерны другим женщинам. Нормальными считаются показатели от 0 до 5%. Если же определяется рост, врачи, прежде всего, начинают подозревать аллергические проявления или же присутствие глистной инвазии.
В отдельных случаях отклонение от нормы может быть спровоцировано употреблением некоторых продуктов питания. Практика показывает, что такое отклонение часто возникает после употребления цитрусовых фруктов.
Редко, но всё-таки некоторым беременным приходится сталкиваться с такими внешними проявлениями эозинофилии:
- покраснение кожи;
- шелушение;
- лёгкий зуд.
Итак, эозинофилия может быть кратковременным явлением и не указывать на развитие проблемы. Однако часто именно она сигнализирует о серьёзных заболеваниях, лечение которых должно быть начато незамедлительно
Заниматься самолечением и самостоятельной диагностикой нельзя, важно обратиться к лечащему врачу, который сможет определить наличие проблемы со здоровьем, назначить правильное лечение. Если вы желаете сохранить крепкое здоровье, доверьтесь врачу
Эозинофилия у детей: причины, симптомы, лечение
Эозинофилия у детей может вызвать большие опасения у родителей, как по поводу здоровья малыша, так и по поводу здоровья их самих, так как она может носить наследственный характер. Однако не нужно делать ранние выводы. Прежде чем начинать беспокоиться, стоит лучше разобраться в этом вопросе.
Для начала вспомним, что такое эозинофилы. Они являются видом лейкоцитов, образующихся в костном мозге.
Их действие распространяется на ткани, в которые они попадают вместе с кровотоком, то есть их областью является желудочно-кишечный тракт, легкие, кожные покровы и капилляры.
Они выполняют ряд функций: фагоцитарную, антигистаминную, антитоксическую, а также принимают активное участие в аллергических реакциях. Основная их цель — борьба с инородными белками путем их поглощения и растворения.
Приемлемые показатели эозинофилов зависят от возраста. Например, для грудного ребенка нормой будет считаться уровень до восьми процентов, однако для ребенка более старшего возраста это показатель будет уже превышать норму. Для того чтобы диагностировать показатель, нужно сдать развернутый анализ крови.
Так как эозинофилия говорит о каком-то нарушении, происходящем в организме, нужно понять, что может являться причиной такого дифференциального диагноза у детей?
Причины заболевания
Лейкемоидная реакция эозинофильного типа у детей может развиваться по целому ряду причин.
- В организме ребенка эозинофилы могут быть повышены из-за реактивной эозинофилии, являющейся ответом организма на реакции аллергического типа. Чаще всего это бывают лекарственные препараты или коровье молоко. У новорожденных причиной может являться внутриутробная инфекция, что дает повод говорить о наследственной эозинофилии.
Реактивная эозинофилия может являться следствием аллергии
- Глистная инвазия, грибковые поражения и дерматологические заболевания.
- Тропическая эозинофилия, Этот синдром также говорит о том, что произошло поражение паразитами, однако условиями для этого явилось несоблюдение гигиенических норм в условиях повышенной влажности и жары.
- Заболевания крови и злокачественные опухоли.
- Васкулиты.
- Нехватка ионов магния в организме.
- Попадание в организм стафилококков.
Основные симптомы
Ясно, что симптомы эозинофилии зависят от основного заболевания, от его проявлений. Некоторые из таких заболеваний мы упомянули в предыдущем подзаголовке. Стоит отметить, что уровень эозинофилов может превышать двадцать процентов. В таком случае имеет место гиперэозинофильный синдром, который говорит о том, что началось поражение сердца, легких и головного мозга.
В предыдущем подзаголовке мы также отметили такую причину, как синдром тропической эозинофилии. Такой синдром имеет свои симптомы:
- одышка;
- астматический кашель;
- эозинофильные фильтраты в легких.
Так как лейкемоидная реакция эозинофильного типа может происходить в следствии некоторых кожных заболеваний, не нужно пропускать мимо их признаки. Такими заболеваниями могут быть: кожный лишай, дерматит, пузырчатка, экзема и так далее.
Диагностика болезни
Ясно, что диагноз ставится на основе анализа периферической крови. После проведения такового обычно нет необходимости в том, чтобы подсчитывать абсолютное число эозинофилов. Врачу необходимо уточнить анамнез, включая информацию об аллергиях, путешествиях, употребляемых медикаментах. Диагностические тесты включают в себя проведение дополнительных исследований:
- анализ мочи;
- анализ кала;
- рентгенография органов грудной клетки;
- серологические исследования;
- функциональные тесты почек и печени;
Если не найти причину эозинофилии, то пациент может находиться в большой опасности, так как не получится назначить эффективное лечение.
Методы лечения
Реактивная эозинофилия не предполагает индивидуального лечения. Количество эозинофилов постепенно снизится, так как будет проводиться лечение основного заболевания, которое вызвало такое изменения в крови.
Если у пациента в процессе диагностики подтвердилось наличие серьезных заболеваний, которые спровоцировали гиперэозинофильный синдром, или наследственной эозинофилии, то могут быть назначены препараты, которые подавляют выработку в больших количествах такой группы лейкоцитов. После проведения курса лечения нужно снова сдать анализ крови.
Если не тянуть с лечением и не ждать, пока симптомы заболеваний пройдут сами по себе, а такого не случится, то получится избежать серьезных последствий и сохранить свое здоровье на приемлемом уровне, который не угрожает драгоценной жизни.
Эозинофилы при гельминтозах
Частой причиной повышения эозинофилов у детей становится заражение глистами. Присутствие гельминтов в организме ребенка устанавливается при помощи анализов:
- кала – диагностика, за исключением аскариды и лямблий, не точная, т. к. не выявляет личинки, продукты жизнедеятельности, метод не работает, если очаг заражения вне пищеварительного тракта;
- крови – общий анализ, печеночные пробы;
- ИФА – иммуноферментный анализ, определяет присутствие антител в крови к определенным видам гельминтов.
Самый надежный способ обнаружения паразитов — это ИФА крови. Этот способ позволяет не только установить вид гельминта, но и выявить уровень зараженности организма.
С помощью ИФА, например, диагностируют заражение токсокарами. Если титр антител к антигенам данного вида паразитов превышает 1 : 800, то больной заражен и является носителем болезни. При ИФА 1 : 3200 эозинофилы в крови у ребенка повышены до 35 – 40%, и это состояние говорит о высокой степени зараженности гельминтами.
Виды гельминтозов
Токсокароз способен протекать у детей с симптомами бронхита, пневмонии. Для состояния больного характерны кашель, повышение температуры в сочетании с кишечным расстройством.
Вызывается токсокароз паразитическими червями токсокарами. Личинки токсокар с током крови попадают в легкие, глаза, почки, мышцы. Взрослые формы паразитируют в кишечнике.
Токсины, которые выделяются в процессе жизнедеятельности паразитических червей, вызывают аллергическую реакцию, сопровождающуюся повышенными до 70 – 80% эозинофилами и высокими IgE.
Признаком токсокароза служат:
- боль в животе;
- кожные высыпания;
- увеличение печени и лимфоузлов.
До 80% повышаются эозинофилы у детей при тропической эозинофилии. Это заболевание вызывается паразитами нематодами, ленточными червями, аскаридами, эхинококками, анкилостомами.
Тропическая легочная эозинофилия сопровождается повышенной температурой, сухим кашлем, астматическим дыханием. Для детей характерны увеличенные в размерах лимфоузлы, печень. Ребенок теряет в весе, в крови повышены эозинофилы до 90%, высокие общие лейкоциты, повышенные до 50*109/л.
Повышение EO при паразитозах
Заражение любым из 98 известных видов паразитов, распространенных на территории РФ, вызывает повышенные эозинофилы. В зависимости от агрессивности паразита и его количества в организме, EO могут быть повышены от 7 – 8% до 80 – 90%.
До 12 — 50% повышены эозинофилы, повышена до 8 – 12 мм в час СОЭ при описторхозе. Вид паразитоза можно предположить не только по показателям эозинофилов, но и по характеру их изменения во время болезни.
Так, если сначала эозинофилы в крови у ребенка повышены до 85%, а через 3 недели снижаются до 8% – 10%, то это значит, скорее всего, что он заражен трематодами.
Повышаются EOS в анализе крови при заражении простейшими одноклеточными. Из 50 видов простейших, способных паразиторовать в организме человека, самой частой причиной паразитозов служит заражение лямблиями.
По данным ВОЗ в разных странах мира лямблиями заражено от 30 до 60% детей. Лямблиозу сопутствуют атопический дерматит, крапивница, пищевая аллергия. Повышение эозинофилов при лямблиозе стойкое, но повышение показателей чаще незначительное и составляет 8% – 10%, хотя отмечаются случаи с EO 17 — 20%.
Как и при каких условиях вырабатываются
Эозинофилы у ребенка (норма зависит от возраста) и взрослого вырабатываются в костном мозге при условии его нормального функционирования. Процесс созревания этих клеток занимает от 6 до 8 дней. Конкретный срок зависит от индивидуальных особенностей организма. На первом этапе в костном мозге формируется универсальная клетка, названная предшественником.
Она является начальной стадией почти для всех клеток. После этого предшественник становится монобластом. Этот вид по своему строению ужу больше похож на эозинофил. Следующий этап формирования – эозинофильный промиелоцит. Его размер меньше, чем у зрелого эозинофила.
После этого промиелоцит превращается в миелоцит, а тот, в свою очередь, в метамиелоцит. Следующая форма – палочкоядерный эозинофил. Эти клетки также называют незрелыми, поскольку они не способны полноценно выполнять свою функцию. После фазы палочкоядерного эозинофила формируется полноценная сегментоядерная клетка, которая уже может поступить в кровеносное русло.
В крови зрелые эозинофилы присутствуют не более 4 дней, после чего распределяются по организму, концентрируясь в тканях. На протяжении 10-14 дней клетки находятся в органах и тканях, защищая их от чужеродных микроорганизмов. После этого клетки погибают. При необходимости головной мозг дает команду костному мозгу для образования новой колонии эозинофилов.
Какими симптомами может сопровождаться эозинофилия
Клиническая картина заболевания не зависит от уровня эозинофильных клеток в крови и от возраста больного. В случае вторичной патологии на выраженность симптомов в большей степени влияет основное заболевание. Поражения органов и систем, которые сопровождаются эозинофилией, могут проявляться как у взрослых, так и у детей со стороны:
- кожи — высыпаниями мигрирующего характера, выраженным зудом ягодиц, рук, стоп, ладоней, спины и белесоватыми уплотнениями, углублениями ногтевых пластинок;
- костно-мышечной системы — болью и слабостью в мышцах, нарушениями координации, воспалениями суставов;
- лимфатической системы — увеличением лимфатических узлов, узелковыми образованиями в области головы и шеи;
- лёгких — лёгочными инфильтратами (уплотнениями в лёгочной ткани мигрирующего характера), сухими и влажными хрипами, приступами кашля, громким утруднённым дыханием;
- сердца — частым сердцебиением, отёками на ногах, одышкой при вдохе;
- пищеварительной системы — болезненностью вокруг пупка, урчанием в животе, увеличением селезёнки и печени, выделением крови с каловыми массами;
- мочеполовой системы — воспалениями мочевого пузыря, язвами слизистых оболочек половых органов;
- нервной системы — общей слабостью, снижением или отсутствием чувствительности в одной половине тела, нарушением координации;
- глаз — конъюнктивитами, кератитами.
Наблюдается он чаще у молодых мужчин, без признаков аллергии или паразитарной инвазии, но с симптомами:
- лихорадки;
- снижения массы тела;
- анемии.
Клиника синдрома напоминает онкологический или инфекционный процесс, поэтому диагноз устанавливается только после исключения данных патологий. Несмотря на отсутствие явной причины заболевания, оно также может иметь разнообразную симптоматику со стороны других органов и систем.
Гиперэозинофилия у беременных женщин
Повышение уровня эозинофилов у женщин в период вынашивания ребёнка может говорить о глистной инвазии или аллергической реакции. Проявляется данное состояние в лёгкой форме и после тщательной диагностики и верно подобранного лечения проходит.
Норма количества эозинофилов в крови у взрослых
Для взрослого человека норма этих клеток колеблется от 1 до 5 % от общего количества лейкоцитов. Определяют их концентрацию с помощью метода проточной цитометрии, используя полупроводниковый лазер. Норма у взрослых мужчин и женщин совпадает. Реже вычисляют число клеток в 1 мл крови. В таком случае в норме их присутствует от 120 до 350 в 1 мл крови.
Их концентрация может варьироваться на протяжении суток в зависимости от работы надпочечников. К примеру, утром эозинофилы в крови повышены на 15% от нормы, а в первую половину ночи – на 30%.
Чтобы получить достоверный результат анализа крови, нужно проходить исследование натощак; за двое суток до предполагаемой даты перестать употреблять алкоголь и сладости. Стоит отметить, что у женщин их количество может варьироваться в зависимости от дней цикла. Например, со дня овуляции и до конца цикла их уровень постепенно снижается. Этот факт позволяет проводить эозинофильный тест функции яичников и определять дни овуляции. Эстрогены ускоряют созревание клеток, прогестерон, наоборот, снижает.
Проявления и отдельные виды эозинофилии как самостоятельной патологии
Симптомы эозинофилии как таковой выделить невозможно, ведь она не является самостоятельным заболеванием, но в ряде случаев вторичного характера повышенных эозинофилов симптомы и жалобы пациентов очень схожи.
Для паразитарных заболеваний характерными симптомами могут быть:
- Увеличение лимфоузлов, печени и селезенки;
- Анемия — особенно, при поражении кишечника, малярии;
- Снижение массы тела;
- Постоянная субфебрильная лихорадка;
- Боли в суставах, мышцах, слабость, снижение аппетита;
- Приступы сухого кашля, сыпь на коже.
Пациент предъявляет жалобы на постоянное чувство усталости, снижение веса и ощущение голода даже при обильном питании, головокружения при анемии, лихорадку, существующую длительно без явной видимой причины. Эти симптомы говорят об интоксикации продуктами обмена паразитов и нарастании аллергии на них, разрушении тканей организма, расстройствах пищеварения и обмена.
Аллергические реакции проявляются зудом кожи (крапивница), образованием волдырей, отеком тканей шеи (отек Квинке), характерной уртикарной сыпью, в тяжелых случаях возможен коллапс, резкое падение артериального давления, отслоение участков кожи и шок.
Поражения пищеварительного тракта с эозинофилией сопровождаются такими симптомами, как тошнота, расстройства стула в виде диареи, рвота, боль и неприятные ощущения в животе, выделение крови или гноя с калом при колитах и т. д. Симптоматика связана не с повышением эозинофилов, а с конкретным заболеванием желудочно-кишечного тракта, клиника которого и выходит на первый план.
Признаки опухолевой патологии, приводящей к эозинофилии вследствие поражения лимфоузлов и костного мозга (лейкозы, лимфомы, парапротеинемии) — лихорадка, слабость, уменьшение массы тела, боль и ломота в суставах, мышцах, увеличение печени, селезенки, лимфоузлов, склонность к инфекционно-воспалительным заболеваниям.
кожные геморрагии, сопровождающиеся эозинофилией
Синдром Леффлера — одна из разновидностей самостоятельных форм эозинофилии. Причины его точно не установлены, вероятно, ими могут быть паразиты, аллергены из воздуха, лекарства. Синдром протекает благоприятно, жалобы или отсутствуют, или больной отмечает кашель, небольшое повышение температуры.
В легких при синдроме Леффлера образуются скопления эозинофилов, которые разрешаются сами собой, не оставляя последствий, поэтому патология заканчивается полным выздоровлением. При выслушивании в легких могут быть выявлены хрипы. В общем анализе крови на фоне множественных эозинофильных инфильтратов в легких, выявляемых при рентгенографии, появляется лейкоцитоз и эозинофилия, иногда достигающая 60-70%. Рентгенологическая картина поражения легочной ткани сохраняется до месяца.
В странах с жарким климатом (Индия, Африканский континент) встречается так называемая тропическая эозинофилия, при которой также в легких появляются инфильтраты, в крови нарастает число лейкоцитов и эозинофилов. Предполагается инфекционная природа патологии. Течение тропической эозинофилии — хроническое с рецидивами, но возможно спонтанное излечение.
При легочной локализации эозинофильных инфильтратов эти клетки обнаруживаются не только в периферической крови, но и в выделениях из дыхательных путей. Эозинофилия мокроты и слизи из полости носа характерна для синдрома Леффлера, тропической эозинофилии, бронхиальной астмы, аллергических ринитов, сенной лихорадки.
Другой возможной локализацией тканевых эозинофильных инфильтратов могут стать мышцы, в том числе, и миокард. При эндомиокардиальном фиброзе происходит разрастание соединительной ткани под внутренним слоем сердца и в миокарде, полости уменьшаются в объеме, нарастает сердечная недостаточность. Биопсия сердечной мышцы показывает наличие фиброза и эозинофильного пропитывания.
Эозинофильный миозит может выступать в качестве самостоятельной патологии. Он характеризуется поражением мышц воспалительного характера с нарастающей эозинофилией в крови.
Эозинофилы повышены у взрослого: причины, как лечить
Если эозинофилы повышены у взрослого, то причиной могут быть болезни легких, крови, органов пищеварения, гормональные, иммунные и прочие нарушения, лечить их необходимо препаратами с антиаллергическим, противовоспалительным, противоопухолевым действием.
Болезни легких
Легочная эозинофилия характеризуется повышением эозинофилов не только в крови, но и мокроте, образованием очагов уплотнения (инфильтратов) в легких. Так протекает:
- эозинофильная пневмония – острая, хроническая;
- легочной аспергиллез – грибковая инфекция, повышение эозинофилов бывает только при обострении;
- гранулематоз Черджа-Стросса – поражены сосуды и есть очаги в легких, процент эозинофильных клеток в лейкоцитарной формуле доходит до 50%.
Улучшение при этих болезнях наступает только при использовании гормонов (Преднизолон, Дексаметазон).
Эозинофильная пневмония
Рак крови
При опухолях крови может быть повышение эозинофилов из-за усиленного их образования в костном мозге. При лейкозах характерно медленное, но устойчивое увеличение клеток до 60-70%, а их уменьшение возможно только при применении противоопухолевых препаратов.
Патологии системы пищеварения
Чаще на фоне наследственной предрасположенности в ответ на определенный вид пищи начинается усиленная миграция (переход) эозинофилов в слизистые оболочки. Так возникает эозинофильное воспаление:
- желудка (гастрит),
- кишечника (энтероколит),
- пищевода (эзофагит).
Для лечения важно обнаружить пищевую непереносимость и исключить продукт из рациона. Эозинофильное воспаление желудка
Эозинофильное воспаление желудка
Гормональные нарушения
Гормоны коры надпочечников, а особенно кортизол, стимулируют гибель эозинофилов, которая является естественной реакцией организма, направленной на регуляцию иммунного ответа. Если гормона мало, то возникает эозинофилия. Основные причины:
- недостаточность – болезнь Аддисона (туберкулезного или аутоиммунного происхождения);
- врожденные заболевания с низкой функцией коры;
- патологии гипофиза – сосудистые, инфекционные, травматические с понижением образованием адренокортикотропина.
Лечение проводится препаратами из группы кортикостероидов – Гидрокортизон, Метипред.
Иммунодефицит и аутоиммунные болезни
Эозинофилия нередко сопровождает нарушения системы иммунной защиты. При врожденных болезнях (Джоба, Вискотта-Олдрича) прогноз неблагоприятный, а приобретенные формы протекают с поражением соединительной ткани:
- ревматоидный артрит,
- узелковый периартериит,
- системная склеродермия.
При них возможно достигнуть улучшения состояния при помощи гормональных препаратов.
Раковые опухоли
С эозинофилией протекают новообразования легких, системы пищеварения, мочеполовой. Повышение показателей происходит медленно, но достигает до 30%, выраженный рост сопровождает метастазирование и распад тканей. Возврат к норме возможен только после удаления и химиотерапии противоопухолевыми средствами.
Смотрите на видео об анализе крови при раке:
Аллергические заболевания
Нарастание количества эозинофилов в крови может означать обострения болезней с аллергическим механизмом развития:
- бронхиальная астма,
- поллиноз,
- экзема,
- атопический дерматит,
- насморк при аллергии,
- медикаментозная непереносимость.
К лекарствам, которые чаще всего провоцируют аллергию, относятся:
- антибиотики,
- ацетилсалициловая кислота,
- эуфиллин,
- средства от туберкулеза,
- витамины группы В,
- сердечные препараты,
- женские половые гормоны,
- контрацептивы.
При лекарственной аллергии требуется отмена препарата, при заболеваниях используют медикаменты из группы антиаллергических, облегчающих дыхание (сосудосуживающие капли в нос, бронхорасширяющие при астме), при кожных болезнях применяют мази с гормональными компонентами.
Прочие причины
У взрослого пациента причинами повышенных эозинофилов также могут быть:
- лямблии (простейшие);
- заражение глистами;
- гонорея;
- туберкулез;
- инфаркт миокарда (неблагоприятный признак);
- период выздоровления после инфекций;
- эндокардит (воспаление внутренней оболочки сердца, клапанов), миокардит (воспалительный процесс в сердечной мышце);
- недостаток магния.
Нормализация состава крови возможна после устранения основного заболевания.
Непатологические причины повышения
Эозинофилы могут быть повышены у взрослого по следующим непатологическим причинам:
- заболевание крови (в частности, серповидно-клеточная анемия — неверная форма эритроцитов провоцирует увеличение скорости их оседания, и будет существенно отличаться от показателей по нормативу);
- наличие инфаркта или инсульта (такие случаи воспаления, когда острофазовые белки адсорбируются в поверхность кровяных клеток, и снижают их электрический заряд);
- болезни, которые связаны с нарушенным обменом веществ (при сахарном диабете, муковисцидозе, ожирении);
- бронхиальная астма;
- болезни печени и проблемы с желчевыводящими путями.
Вопрос-ответ
Что такое эозинофилы и какую роль они играют в организме?
Эозинофилы — это тип белых кровяных клеток, которые играют важную роль в иммунной системе, особенно в борьбе с аллергиями и паразитарными инфекциями. Они также участвуют в воспалительных процессах и помогают регулировать иммунный ответ.
Какие причины могут привести к повышению уровня эозинофилов в крови?
Повышение уровня эозинофилов, или эозинофилия, может быть вызвано различными факторами, включая аллергические реакции, инфекции, вызванные паразитами, аутоиммунные заболевания, а также некоторые виды рака и реакции на лекарства.
Что может свидетельствовать о понижении уровня эозинофилов в крови?
Пониженный уровень эозинофилов, или эозинофилия, может указывать на различные состояния, такие как острые инфекции, стресс, использование кортикостероидов или другие заболевания, которые подавляют иммунный ответ. Важно проконсультироваться с врачом для определения причины.
Советы
СОВЕТ №1
Регулярно проходите медицинские обследования, чтобы контролировать уровень эозинофилов в крови. Это поможет выявить возможные отклонения на ранних стадиях и своевременно обратиться к врачу.
СОВЕТ №2
Обратите внимание на свое питание и образ жизни. Употребление антиоксидантов, витаминов и минералов может помочь поддерживать нормальный уровень эозинофилов и укрепить иммунную систему.
СОВЕТ №3
Если у вас есть аллергии или хронические заболевания, такие как астма, обязательно консультируйтесь с врачом о том, как они могут влиять на уровень эозинофилов и какие меры можно предпринять для их контроля.
СОВЕТ №4
Не игнорируйте симптомы, такие как зуд, высыпания или респираторные проблемы. Эти проявления могут указывать на повышение уровня эозинофилов и требуют медицинского внимания.